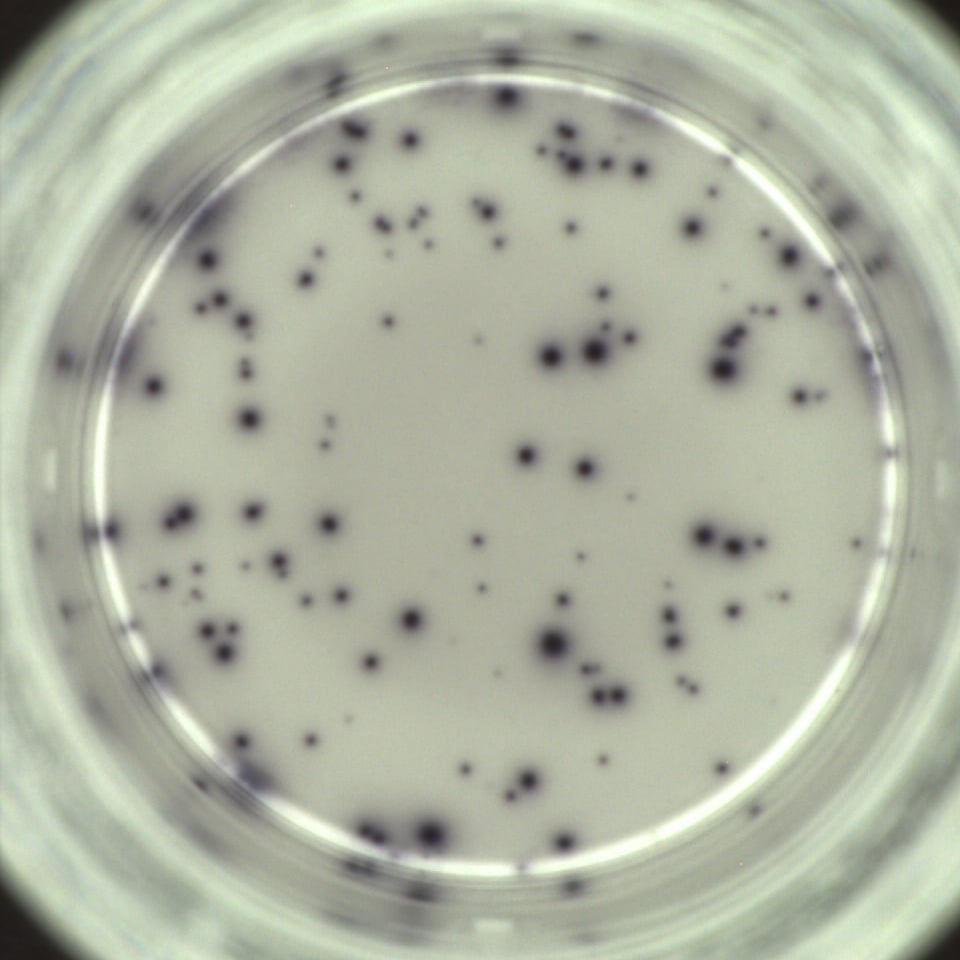

Over ons
De kracht van klein, de ambitie van groot!
Innatoss is een onderzoeks-intensieve organisatie. We zijn experts in serologische en cellulair-immunologische testen met jaren ervaring in de Life Sciences, zowel academisch als industriëel. We werken nauw samen met patiëntenverenigingen en universiteiten. Zo verzekeren we ons van zinvolle én wetenschappelijk goed onderbouwde innovaties.
Wij hebben een duidelijke visie: door betere diagnostiek chronische infectieziekten de wereld uit helpen. We doen dat met onderzoek naar onder andere Lymeziekte, COVID-19 en Q-koorts. We zetten bewust in op een beperkt aantal infectieziekten. Dat geeft ons team de kans zich te specialiseren en testmethodes te ontwikkelen die zich echt onderscheiden ten opzichte van bestaande producten.
Innatoss Laboratories is een expertiselaboratorium voor Lymeziekte.

De Raad voor Accreditatie heeft Innatoss als testlaboratorium geaccrediteerd op basis van de norm ISO/IEC 17025:2017. Klik hier voor meer informatie of stuur uw vraag aan info@innatoss.com.
Daarnaast voldoet Innatoss aan NEN 7510:2024, de huidige norm voor informatiebeveiliging in de zorg.
Daarnaast voldoet Innatoss aan NEN 7510:2024, de huidige norm voor informatiebeveiliging in de zorg.
0
Jaar test ervaring
0
Partner organisaties
0+
Afgenomen testen per jaar
0+
Mensen geholpen
Onze visie en missie, aangevuld met onze kernwaardes, geven een scherpe focus in de strijd tegen infectieziekten.
Onze Visie
Met betere diagnostiek chronische infectieziekten de wereld uit helpen. We zetten bewust in op een beperkt aantal infectieziekten. Dat geeft ons team de kans zich te specialiseren en testmethodes te ontwikkelen die zich écht onderscheiden.
Onze Missie
Onze focus op infecties met een langdurig verloop voorziet ons van nieuwe inzichten in de afweerreactie tegen bacteriële en virale infecties. Die kennis gebruiken we om nieuwe, innovatieve diagnostische testen op de markt te brengen, vaak in samenwerking met partners. Slimme toepassing van bestaande testen hoort hier ook bij.
Onze activiteiten
Innatoss door de jaren heen
Waar diagnostiek en onderzoek samen komen
Wij maken Innatoss
Maak kennis met onze professionals
Onze mix van kennis, ervaring, drive en energie zorgt voor een inspirerende en betrokken teamsfeer. Samen zetten we stappen vooruit om onze missie te bereiken: nieuwe oplossingen ontwikkelen en beschikbaar maken voor iedereen.
Anja Garritsen
Algemeen Directeur
Elena Volokhina
Sr Scientist Diagnostiek
Saskia Theunisse
Office Manager/Coördinatie
Willemijn Anker
Clinical Trial Assistant
Milou Kouwijzer
Kwaliteits- en IT manager
Jordi Lankhof
ICT expert/ Labmedewerker
Yesper Smits
Senior Labmedewerker
Mats van Kempen
Labmedewerker/Productspecialist
Caroline Axinte
Doktersassistente
Petra de Vries
Doktersassistente
Petra Dekkers
Doktersassistente
Luc van Galen
Arts, BIG: 79931770401
onze identiteit
5 kernwaardes als kompas
Betrokken, Authentiek, Ambitieus, Verstandig en Vasthoudend
Betrokken
We geven 100% in de strijd tegen infectieziekten en werken daarbij nauw samen met alle betrokkenen: patiënten, risicogroepen, medische professionals en partners in overheid, organisaties en bedrijfsleven. Samen verminderen we de gezondheidsproblemen die infectieziekten veroorzaken.
Authentiek
Wij geloven in ieders unieke eigenschappen en karakters. Van collega’s en partners tot medici en patiënten. We geloven in het volgen van je eigen pad en de verrassingen die daarbij horen. Juist die diversiteit aan inzichten brengt ons richting slimme, unieke oplossingen.
Ambitieus
We streven ernaar onze ambitieuze missie waar te maken: in korte tijd bijdragen aan het verminderen van gezondheidsproblemen door infectieziekten. Met onze inzet en sterke samenwerkingen met de juiste partners werken we doelgericht aan echte impact.
Verstandig
Wij waarderen doordachte keuzes. Slimheid in balans met intuïtie, juist wanneer de puzzel nog niet compleet is. Innovatie draait voor ons niet alleen om trial and error, maar om trial, error én analyse! Door verstandige aanpassingen op basis van feiten én ervaring brengen we nieuwe ideeën tot leven.
Vasthoudend
We houden onze koers vast ondanks tegenwerking of tegenslag. Om ons doel te bereiken moeten we soms een nieuwe weg vinden en de uitdagingen daarop zien te overwinnen. Uiteindelijk zullen we op die manier succesvol zijn, zoals Thomas Edison zei “Ik heb niet gefaald. Ik heb met succes 10.000 manieren gevonden die niet werken.” En toen was er licht.